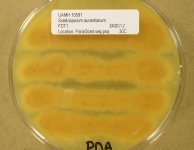

<< back to search
IMAGES:






Search Details
add to cart
| UAMH Number: | 10591 |
|---|---|
| Species Name: | Scedosporium apiospermum |
| Type: | |
| Synonyms: | Acremonium suis / Actinomyces albus / Actinomyces tarozzii / Aleurisma apiospermum / Dendrostilbella boydii / Glenospora clapieri / Glenosporopsis clapieri / Indiella americana / Madurella americana / Madurella clapieri / Monosporium apiospermum / Monosporium apiospermum var. peperei / Monosporium sclerotiale / Polycytella hominis / Scedosporium sclerotiale / Streptothrix tarozzii / Trichosporum clapieri |
| Taxonomy: | FUNGI Ascomycota, Sordariomycetes, Microascales, Microascaceae |
| Strain History: | Rennie, R. (MY 5253) -> UAMH |
| Substrate: | unknown specimen, male 28 yr | Location: | CANADA New Brunswick, Moncton (GEO: 46.128,-64.88) |
| Isolator: | |
| Isolation Date: | 2005-06-23 |
| Date Received: | 2005-09-27 |
| Characters: | CULTURE CONDITIONS produced Scedosporium and Graphium states but no ascomata // CYCLOHEXIMIDE slightly sensitive // MOLECULAR SYSTEMATICS Blast match 100% ITS similarity to Pseudallescheria boydii AY877350 = CBS 101.22 = UAMH 3982 T - fide UAMH 2012 // PIGMENT yellow // THERMOTOLERANT grows better @ 35C than @ 30C |
| Compounds: | |
| Cross Reference: | MY 5253 // OMH FR 800 |
| Pathogenic Potential: | Human: yes | Animal: yes | Plant: no |
| Biosafety Risk Group: | RG2 (check the PHAC ePATHogen Risk Group Database for updates) |
| Regulatory Requirements: | Canadian requesters must provide PHAC Pathogen and Toxin License Number (see: https://www.canada.ca/en/public-health/services/laboratory-biosafety-biosecurity/licensing-program.html) prior to shipment. International requesters must provide all legally required importation documentation prior to shipment. Plant pathogenicity status may be verified by using the USDA Agricultural Research Service (ARS) Fungal Database |
| MycoBank ID: | 432048 |
| Sequences: | >UAMH10591_ITS CATTACAGAGTTACTACTCCAAACCCATTGTGAACCTTACCTATGTTCTGTTGCCTCGGCGGCGTCGGTCAGCGCCCCTCTGAAAAGAGGACGATGCCCCTCCCGCCGGCAGCACCAAACTCTTGAATTTTACAGCGGATTACAGTTCTGATTTGAAAACAAAAAACAAGTTAAAACTTTCAACAACGGATCTCTTGGTTCTGGCATCGATGAAGAACGCAGCGAAATGCGATAAGTAATGTGAATTGCAGAATTCAGTGAATCATCGAATCTTTGAACGCACATTGCGCCCGGCAGTAATCTGCCGGGCATGCCTGTCCGAGCGTCATTTCAACCCTCGAACCTCCGTTTCCTTAGGGAAGCCTAGGGTCGGTGTTGGGGCGCTACGGCGAGTCCTCGCGACCCCCGTAGGCCCTGAAATACAGTGGCGGTCCCGCCGCGGTTGCCTTCTGCGTAGTAAGTCTCTTTTGCAAGCTCGCATTGGGTCCCGGCGGAGGCCTGCCGTCAAACCACCTAACAACTCCAGATGGTTTGACCTCGGATCAGGTAGGGTTACCCGCTGAACTTAAGCATATCAATAAGCGGAGGAAAAGAAACCAACAGGGATTGCCTCAGTAACGGCGAGTGAAGCGGCAAC |
IMAGES: